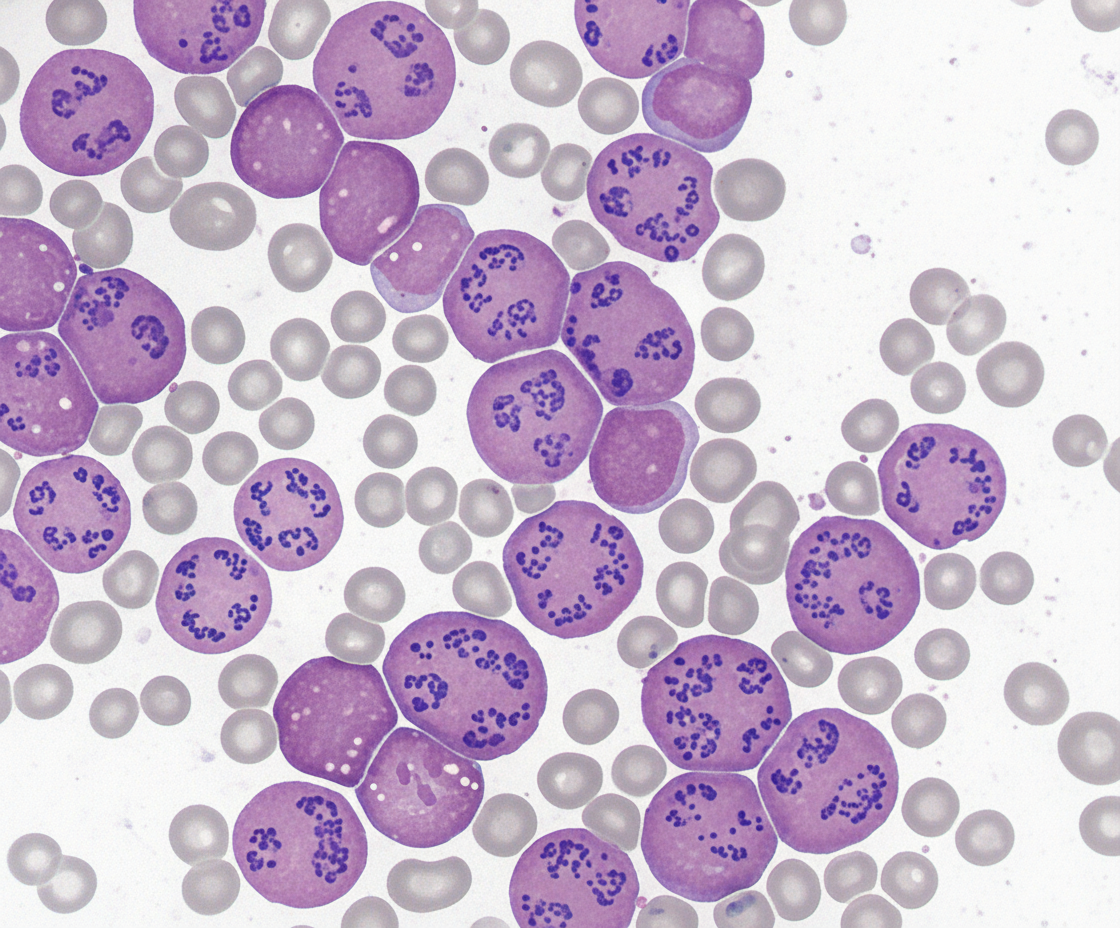
Image for question 12

Enter your email to get your 85% OFF code and unlock the full NEET PG question bank on the app.
Poikilocytosis is due to difference in:
Spot the diagnosis?
A 1-year-old girl presents with a 3-day history of fever and diarrhea. Her temperature is 38°C (101°F). A CBC reveals a normal WBC count and an increased hematocrit of 48 g/dL. What is the most likely cause of the elevated hematocrit in this patient?
Which statement is false regarding hemolytic anemia?
All of the following are preleukemic conditions, except:
Basophilic stippling is seen with which of the following conditions?
Which of the following is a consequence of extravascular hemolysis?
Peripheral smear may show vacuolated lymphocytes in all of the following conditions EXCEPT?
Which immunoglobulin is typically implicated as a warm antibody in autoimmune hemolytic anemia?
Which type of leukemia is associated with Disseminated Intravascular Coagulation?
Anemias: Classification and Approach
Practice Questions
Hemolytic Anemias
Practice Questions
Myeloproliferative Neoplasms
Practice Questions
Myelodysplastic Syndromes
Practice Questions
Acute Leukemias
Practice Questions
Chronic Leukemias
Practice Questions
Lymphomas and Lymphoid Neoplasms
Practice Questions
Plasma Cell Disorders
Practice Questions
Bleeding Disorders
Practice Questions
Thrombotic Disorders
Practice Questions
Get full access to all questions, explanations, and performance tracking.
Scan to download app